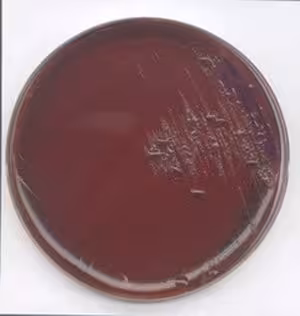

Promotion Gauss réactifs
10067 produits - Trié par pertinence
MACS DYKDDDDK Isolation Kit/1 kitfor 40 isolations
Réf. UGAP : 3729982 Réf. constructeur : 130-101-591
MACS Protein G MicroBeads/for 20 40 immunoprecipitations
Réf. UGAP : 3729388 Réf. constructeur : 130-071-101
MACSplex Mix Cytotoxic IL-21 Reagent human/for up to 100 tests
Réf. UGAP : 3730929 Réf. constructeur : 130-125-815
PepTivator B. afzelii ospB research grade/6 nmol/peptide for stimulation of 1×10E8 cells
Réf. UGAP : 3730627 Réf. constructeur : 130-099-782
PepTivator EBV BRLF1 research grade human/6 nmol/peptide for stimulation of 1×10E8 cells
Réf. UGAP : 3729918 Réf. constructeur : 130-097-284
PepTivator SARS-CoV-2 Prot_S1 research grade/60 nmol/peptide for stimulation of 1×10E9 cells
Réf. UGAP : 3730216 Réf. constructeur : 130-127-048
StraightFrom Buffy Coat REAlease CD8 MicroBead Kit human/1 kit
Réf. UGAP : 3730945 Réf. constructeur : 130-127-139